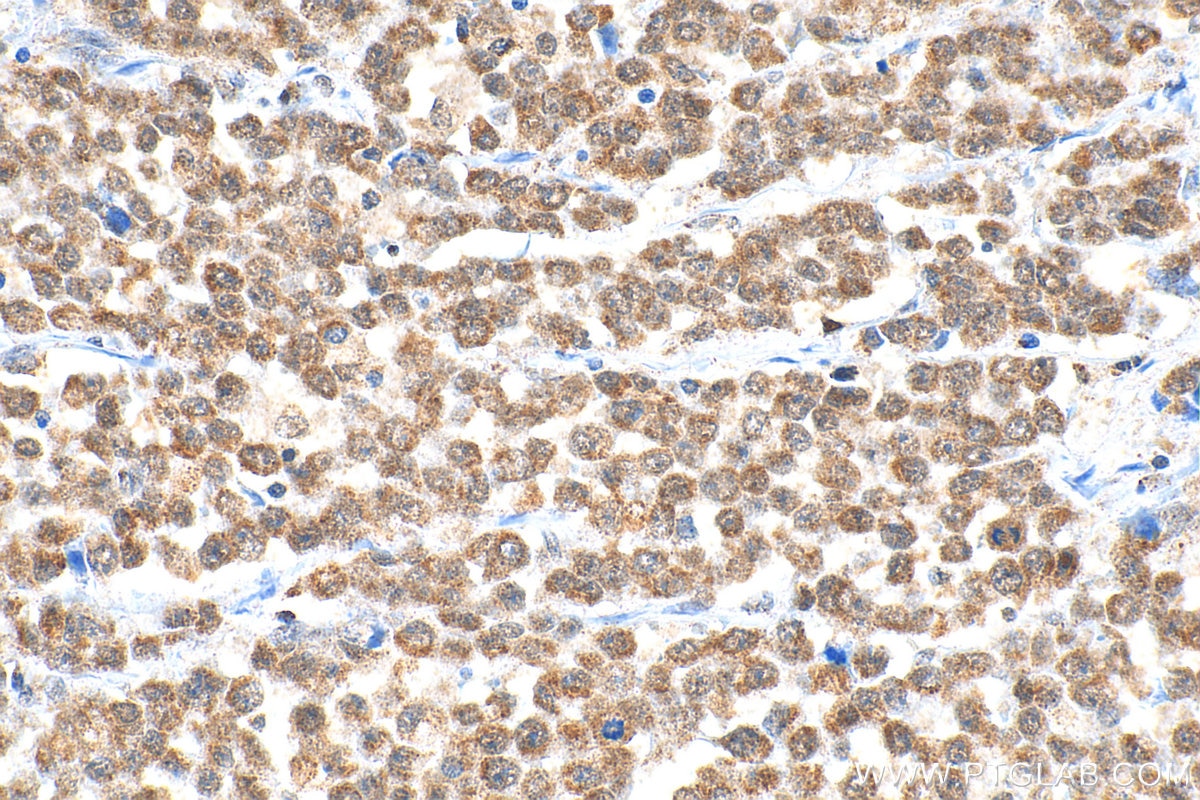
Immunohistochemical analysis of paraffin-embedded human colon cancer tissue slide using 14330-1-AP (ADAR1 antibody) at dilution of 1:200 (under 40x lens). Heat mediated antigen retrieval with Tris-EDTA buffer (pH 9.0). Immunohistochemistry (IHC) staining of human colon cancer tissue using ADAR1 Polyclonal antibody (14330-1-AP)

Tested Applications
| Positive WB detected in | HeLa cells, A431 cells, HepG2 cells, Jurkat cells |
| Positive IP detected in | HepG2 cells |
| Positive IHC detected in | human colon cancer tissue, human gliomas tissue, human stomach cancer tissue, mouse brain tissue, mouse colon tissue Note: suggested antigen retrieval with TE buffer pH 9.0; (*) Alternatively, antigen retrieval may be performed with citrate buffer pH 6.0 |
| Positive IF/ICC detected in | HeLa cells |
Recommended dilution
| Application | Dilution |
|---|---|
| Western Blot (WB) | WB : 1:500-1:2000 |
| Immunoprecipitation (IP) | IP : 0.5-4.0 ug for 1.0-3.0 mg of total protein lysate |
| Immunohistochemistry (IHC) | IHC : 1:50-1:500 |
| Immunofluorescence (IF)/ICC | IF/ICC : 1:200-1:800 |
| It is recommended that this reagent should be titrated in each testing system to obtain optimal results. | |
| Sample-dependent, Check data in validation data gallery. | |
Published Applications
| KD/KO | See 2 publications below |
| WB | See 20 publications below |
| IHC | See 6 publications below |
| IF | See 8 publications below |
| IP | See 1 publications below |
| CoIP | See 2 publications below |
Product Information
14330-1-AP targets ADAR1 in WB, IHC, IF/ICC, IP, CoIP, ELISA applications and shows reactivity with human, mouse, rat, pig samples.
| Tested Reactivity | human, mouse, rat, pig |
| Cited Reactivity | human, mouse, rat |
| Host / Isotype | Rabbit / IgG |
| Class | Polyclonal |
| Type | Antibody |
| Immunogen |
CatNo: Ag5609 Product name: Recombinant human ADAR1 protein Source: e coli.-derived, PET28a Tag: 6*His Domain: 877-1226 aa of BC038227 Sequence: DSEDMGVVVSLGTGNRCVKGDSLSLKGETVNDCHAEIISRRGFIRFLYSELMKYNSQTAKDSIFEPAKGGEKLQIKKTVSFHLYISTAPCGDGALFDKSCSDRAMESTESRHYPVFENPKQGKLRTKVENGEGTIPVESSDIVPTWDGIRLGERLRTMSCSDKILRWNVLGLQGALLTHFLQPIYLKSVTLGYLFSQGHLTRAICCRVTRDGSAFEDGLRHPFIVNHPKVGRVSIYDSKRQSGKTKETSVNWCLADGYDLEILDGTRGTVDGPRNELSRVSKKNIFLLFKKLCSFRYRRDLLRLSYGEAKKAARDYETAKNYFKKGLKDMGYGNWISKPQEEKNFYLCPV Predict reactive species |
| Full Name | adenosine deaminase, RNA-specific |
| Calculated Molecular Weight | 136 kDa |
| Observed Molecular Weight | 110 kDa |
| GenBank Accession Number | BC038227 |
| Gene Symbol | ADAR1 |
| Gene ID (NCBI) | 103 |
| RRID | AB_2273600 |
| Conjugate | Unconjugated |
| Form | Liquid |
| Purification Method | Antigen affinity purification |
| UNIPROT ID | P55265 |
| Storage Buffer | PBS with 0.02% sodium azide and 50% glycerol, pH 7.3. |
| Storage Conditions | Store at -20°C. Stable for one year after shipment. Aliquoting is unnecessary for -20oC storage. 20ul sizes contain 0.1% BSA. |
Background Information
ADAR1 is also named as ADAR1, DSRAD, G1P1, IFI4. It convert selected adenosine residues into inosine in substrate RNAs containing a relatively short dsRNA region(PMID:15556947). The human ADAR1 gene specifies two size forms of RNA-specific adenosine deaminase, an IFN inducible ∼150 kDa protein and a constitutively expressed N-terminally truncated ∼110 kDa protein, encoded by transcripts with alternative exon 1 structures that initiate from different promoters(PMID:11111054). It has 5 isoforms produced by alternative promoter usage and alternative splicing. Defects in ADAR are a cause of dyschromatosis symmetrical hereditaria (DSH).ADAR1 can form respective homodimers, and this association is essential for its enzymatic activities(PMID:17428802).
Protocols
| Product Specific Protocols | |
|---|---|
| IF protocol for ADAR1 antibody 14330-1-AP | Download protocol |
| IHC protocol for ADAR1 antibody 14330-1-AP | Download protocol |
| IP protocol for ADAR1 antibody 14330-1-AP | Download protocol |
| WB protocol for ADAR1 antibody 14330-1-AP | Download protocol |
| Standard Protocols | |
|---|---|
| Click here to view our Standard Protocols |
Publications
| Species | Application | Title |
|---|---|---|
Adv Sci (Weinh) Primate-Specific DAZ Regulates Translation of Cell Proliferation-Related mRNAs and is Essential for Maintenance of Spermatogonia | ||
Dev Cell Genome-wide analysis of pseudogenes reveals HBBP1's human-specific essentiality in erythropoiesis and implication in β-thalassemia. | ||
Neurobiol Stress Roles of miR-432 and circ_0000418 in mediating the anti-depressant action of ADAR1. | ||
J Biol Chem ADAR promotes USP38 auto-deubiquitylation and stabilization in an RNA editing-independent manner in Esophageal Squamous Cell Carcinoma | ||
Am J Cancer Res The aberrant expression of ADAR1 promotes resistance to BET inhibitors in pancreatic cancer by stabilizing c-Myc. | ||
Toxicol Appl Pharmacol The anti-cancer drug candidate CBL0137 induced necroptosis via forming left-handed Z-DNA and its binding protein ZBP1 in liver cells |